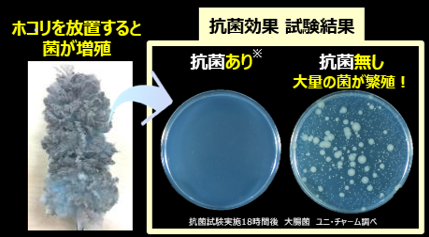

2024年10月25日
お掃除用品『ウェーブ』より、コンフォート・カラー×吸盤フック付企画品を発売
ユニ・チャーム株式会社(代表取締役 社長執行役員:高原 豪久)は、お掃除用品『ウェーブ』より、インテリアにマッチするコンフォート・カラー※1の商品に、吊り下げ収納に便利な「吸盤フック」を付属した企画品を2024年10月29日に発売します。
※1 インテリアに調和し心地よさを感じる色合いのこと。


商品の特長
(1) インテリアとマッチするコンフォート・カラーを採用
・ナチュラルベージュとダークグレーの2色をご用意しました。


(2) 吊り下げ収納に便利な吸盤フック付き
・シートとホルダーがセットになった「本体」には、付属品として吸盤フックをお付けしました。
・吸盤部分は無色クリアー、フック部分はシンプルホワイトを採用。どのような色合いのインテリアにもマッチします。
・使用機会の多い場所に吊り下げて収納することで、ホコリに気づいたときなどに、サッとお掃除することができます。
【設置場所※2例】


※2 吸盤フックを取り付けられない所:凹凸、ザラザラ、つや消し、壁紙などの面。
(3) シートの一部に再生PET※3を採用
・シートにサステナブル素材の再生PETを使用しました。
※3 使用済みのペットボトルなどをリサイクルしたポリエチレンテレフタレート(PET)を原料としたサステナブル素材。
(再生PETを原材料に用いることによって、ホコリなどの吸着性が低下などの機能上の変化はありません)
(4) 無駄なく使えるスマート設計
・大きなホコリや粒ゴミもからめ取って離しません。※4
※4 対象となるホコリやゴミが重過ぎたり量が多過ぎた場合には、取り切れない可能性もあります。


(5) 抗菌※5EXファイバーで、からめ取ったホコリに含まれる菌の増殖を抑制
・ウェーブのシートには抗菌成分を配合しているので、からめ取ったホコリに含まれる菌の増殖を抑制します。
※5 抗菌加工を施した部位の表面でのみ菌の増殖を抑制します。また、すべての菌の抑制をするものではありません。

(6) 舞い上げブロックシート
・表面のシートがホコリの舞い上げをブロックします。
・下記のURLで、ホコリを舞い上げない驚きの機能を動画でご覧いただけます


入数・価格
| 商品名 | 入数 | 価格 |
|---|---|---|
ウェーブ ハンディ本体+1枚 ケース付 |
ハンディ本体1本 取り替えシート1枚 ケース付 |
オープンプライス |
ウェーブ 取り替えシート白×青10枚 |
取り替えシート 白×青10枚 |
|
ウェーブ 取り替えシート白×ピンク10枚 |
取り替えシート 白×ピンク10枚 |
発売時期
2024年10月29日に企画品として発売します。
『ウェーブ』 ブランドサイト
『ウェーブ』 コンフォート・カラー×吸盤フック付企画品の発売を通じて貢献する「SDGs17の目標」
この商品は、2015年に国連で採択された「持続可能な開発目標」(SDGs:Sustainable Development Goals)で定めた17の目標のうち、下記に貢献すると当社では考えています。
3.すべての人に健康と福祉を 12.つくる責任 つかう責任
これからも、商品やサービスの提供といった事業活動を通じて、環境問題や社会課題を解決し、SDGsの達成に貢献することを目指します。
<<本件に関するお問い合わせ先>>
一般報道機関の方は、ユニ・チャーム(株)ESG本部広報室 TEL:03-6722-1019
Email:brand-pr@unicharm.com
消費者の方は、ユニ・チャーム(株)お客様相談センター TEL:0120-573-001
